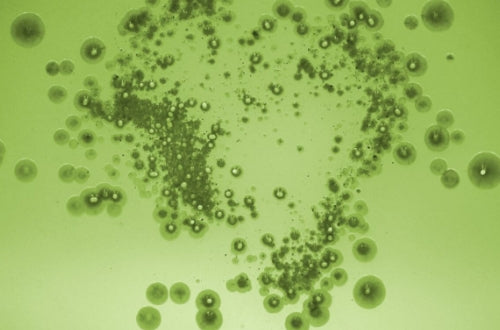

Une meilleure vie grâce à la science du microbiome
Le microbiome humain
Le microbiome humain est un écosystème complexe de micro-organismes indispensables à notre santé. Il influence la digestion, le système immunitaire et bien plus encore.
Cette interaction sophistiquée de micro-organismes met en évidence l'importance de faire des choix de santé éclairés pour améliorer notre bien-être général. Maintenir un microbiome équilibré est crucial pour la résilience et l'équilibre de notre corps et pour préserver une santé optimale.
Une vie meilleure grâce à la science du microbiome
L'étude scientifique du microbiome humain, combinée à la prise de probiotiques, s'avère être une stratégie clé. Les probiotiques sont spécialement conçus pour optimiser les interactions microbiennes, améliorer nos fonctions corporelles et nous protéger contre les maladies. Adopter des probiotiques est une démarche proactive pour vivre de manière plus dynamique et en meilleure santé.
Efficacité scientifiquement prouvée
Nupure se positionne à la pointe du bien-être, en s'appuyant sur une recherche approfondie avec plus de 90 études cliniques qui alimentent l'innovation.
Nos experts en recherche et développement s'engagent à transformer les dernières découvertes scientifiques en avantages concrets pour la santé.
Grâce à un engagement inlassable envers la connaissance et à l'utilisation de technologies de pointe, Nupure s'efforce de fournir des solutions innovantes et basées sur la recherche, reflétant les dernières avancées en matière de santé et de nutrition.
Notre promesse est de vous offrir des produits qui sont non seulement à la pointe des progrès scientifiques, mais aussi adaptés aux besoins évolutifs de votre parcours de santé.
Qualité pharmaceutique

Qualité pharmaceutique
Exigences de qualité strictes
Nupure Probaflor incarne l'excellence en matière de qualité pharmaceutique, répondant aux normes rigoureuses de l'UE à chaque étape de la production. Nos installations en Europe, conçues pour la fabrication de médicaments, respectent les normes de production les plus élevées. Nous mettons un accent particulier sur l'approvisionnement en souches bactériennes auprès de fabricants européens réputés, garantissant une traçabilité complète et des formulations supérieures.
Nous sommes une équipe de scientifiques dévouée qui exploite la puissance des micro-organismes bénéfiques pour une santé et un bien-être optimal. Notre passion nous pousse à mener des recherches rigoureuses et à fournir des produits probiotiques de haute qualité quifavorisent un microbiome équilibré et florissant, soutenant ainsi votre parcours vers une vie plus saine et plus heureuse.
Notre blog pour vous

5 questions sur les ballonnements
Peu de gens aiment parler des ballonnements, pourtant presque tout le monde en souffre, à des degrés divers. Il est normal de relâcher des gaz jusqu'à huit fois par jour. Mais que faire lorsque les ballonnements deviennent vraiment gênants ?
Lire la suite >
Les bactéries intestinales - un soutien pour le système immunitaire ?
Le microbiote intestinal forme avec notre intestin un véritable bioréacteur où se déroulent d'innombrables processus. Ceux-ci assurent que nous recevons les nutriments nécessaires.
Lire la suite >
Besoin d'aide ?
-
E-mail service@nupure.eu
-
Telephone 01.78.90.05.75
Restez informé
Offres exclusives, lancements de produits et dernières nouvelles scientifiques sur le microbiote intestinal dans votre boîte mail.